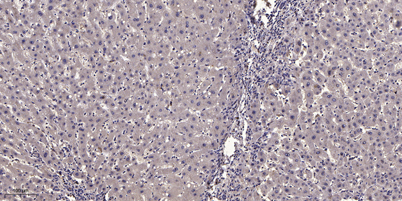

NBPF7 rabbit pAb
 One-click to copy product information
One-click to copy product information$148.00/50µL $248.00/100µL
| 50 µL | $148.00 |
| 100 µL | $248.00 |
Overview
| Product name: | NBPF7 rabbit pAb |
| Reactivity: | Human;Rat;Mouse; |
| Alternative Names: | NBPF7; Putative neuroblastoma breakpoint family member 7 |
| Source: | Rabbit |
| Dilutions: | WB 1:500-2000;IHC-p 1:50-300 |
| Immunogen: | The antiserum was produced against synthesized peptide derived from human NBPF7. AA range:361-410 |
| Storage: | -20°C/1 year |
| Clonality: | Polyclonal |
| Isotype: | IgG |
| Concentration: | 1 mg/ml |
| Observed Band: | 48kD |
| GeneID: | 343505 |
| Human Swiss-Prot No: | P0C2Y1 |
| Cellular localization: | Cytoplasm . |
| Background: | neuroblastoma breakpoint family member 7(NBPF7) Homo sapiens This gene is a member of the neuroblastoma breakpoint family (NBPF) which consists of dozens of recently duplicated genes primarily located in segmental duplications on human chromosome 1. This gene family has experienced its greatest expansion within the human lineage and has expanded, to a lesser extent, among primates in general. Members of this gene family are characterized by tandemly repeated copies of DUF1220 protein domains. Gene copy number variations in the human chromosomal region 1q21.1, where most DUF1220 domains are located, have been implicated in a number of developmental and neurogenetic diseases such as microcephaly, macrocephaly, autism, schizophrenia, mental retardation, congenital heart disease, neuroblastoma, and congenital kidney and urinary tract anomalies. Altered expression of some gene family members is associated with several types of cancer. This gene fam |
-
 Western Blot analysis of various cells using NBPF7 Polyclonal Antibody
Western Blot analysis of various cells using NBPF7 Polyclonal Antibody -
 Western blot analysis of lysates from HT-29 and HepG2 cells, using NBPF7 Antibody. The lane on the right is blocked with the synthesized peptide.
Western blot analysis of lysates from HT-29 and HepG2 cells, using NBPF7 Antibody. The lane on the right is blocked with the synthesized peptide. -
Immunohistochemical analysis of paraffin-embedded human liver cancer. 1, Antibody was diluted at 1:200(4° overnight). 2, Tris-EDTA,pH9.0 was used for antigen retrieval. 3,Secondary antibody was diluted at 1:200(room temperature, 45min).
Immunohistochemical analysis of paraffin-embedded human liver cancer. 1, Antibody was diluted at 1:200(4° overnight). 2, Tris-EDTA,pH9.0 was used for antigen retrieval. 3,Secondary antibody was diluted at 1:200(room temperature, 45min).

 Manual
Manual